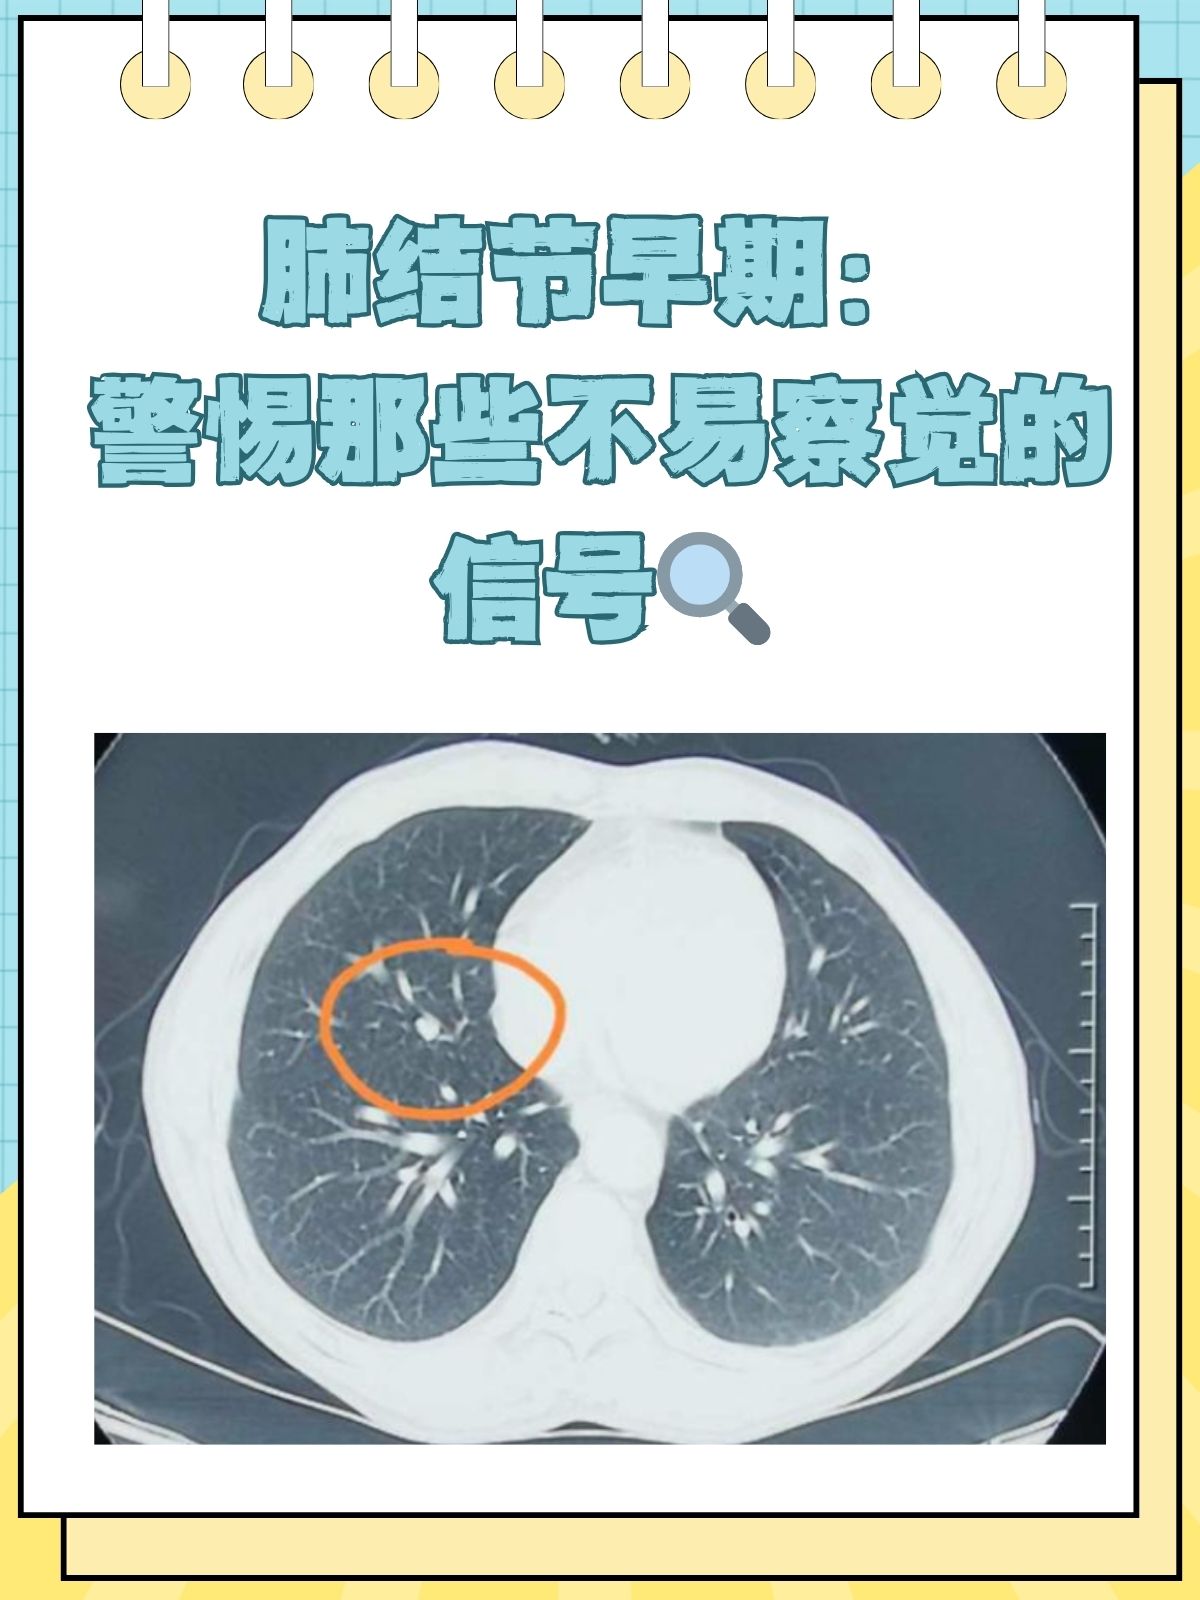
肺结核潜伏期

1、被结核病病人传染后的潜伏期一般为4至8周,但存在个体差异,短则1至2周,长则可达数月甚至数年结核病由结核分枝杆菌引发,主要通过飞沫传播当健康人吸入含结核菌的飞沫后,可能感染结核菌,但并非一定会发病发病与否取决于人体免疫力若免疫力较强,结核菌可能被清除,不引发疾病若免疫力较弱。
2、肺结核的潜伏期通常为数周至数年不等,具体时长受个体免疫力感染结核分枝杆菌的数量及毒力等因素影响多数情况下,感染结核分枝杆菌后48周,机体可能逐渐出现免疫反应相关变化,但潜伏期长短存在显著个体差异免疫力较强者可能因免疫系统有效抑制病原体繁殖,导致潜伏期延长而免疫力低下者如儿童。
3、肺结核的潜伏期通常为2到12周,但个别患者可能长达数年不出现症状肺结核的潜伏期是指个体感染结核分枝杆菌后,病原体在体内繁殖但尚未引发明显临床症状的阶段在此期间,患者通常无自觉不适或典型呼吸道症状,如咳嗽咳痰发热等,因此难以通过症状早期发现感染潜伏期的长短受多重因素影响,包括。
4、肺结核的发病潜伏期是从感染结核分枝杆菌到出现临床症状体征的时间,平均约为3 6个月,但范围可从数周到数年不等,具体受多种因素影响结核分枝杆菌的毒力和数量是决定潜伏期长短的重要因素高毒力菌株感染者潜伏期可能较短,部分人群可能在感染后较短时间内发病而低毒力菌株感染者潜伏期可能。
5、潜伏期时长肺结核潜伏期一般为48周,但具体时长因人而异,可能更短或更长免疫力较强者潜伏期可能延长,而免疫力较弱者可能更早出现症状个体免疫力影响免疫力水平是决定潜伏期长短的关键因素免疫力强的人感染结核菌后,可能长期不发病,但结核菌仍在体内繁殖并逐渐引发肺部炎症免疫力弱者则可能在潜伏期内出现症状,如轻微。
6、肺结核潜伏期一般为2 10个月左右,具体时长受多种因素影响一潜伏期时长范围肺结核潜伏期通常在2 10个月之间,但存在个体差异感染者的机体免疫力感染的结核分枝杆菌数量及毒力是主要影响因素例如,机体免疫力较强时,免疫系统可能更有效地控制病菌复制,延缓发病,使潜伏期延长若感染。
7、肺结核具有潜伏期肺结核由结核分枝杆菌引发,其潜伏期受多重因素影响,主要取决于感染结核菌的数量菌株毒力以及个体免疫状态一般情况下,潜伏期跨度较大,可从数月延续至数年在此阶段,感染者可能无明显症状,但结核菌仍在体内持续繁殖当免疫力下降时如感染HIV患糖尿病长期使用免疫抑制剂。
8、因此,一旦确诊需隔离治疗,并规范使用抗结核药物如异烟肼利福平以控制病情减少传播4 关键区别潜伏性感染与活动性结核 潜伏性结核感染无症状,不传染,但未来可能发病活动性肺结核有症状且传染,需立即治疗总结肺结核无固定潜伏期,但感染后存在从无症状到发病的时间窗口免疫力强。
9、4 潜伏期差异的核心因素潜伏期的长短主要取决于感染结核分枝杆菌的数量和宿主免疫力菌量多免疫力弱时,细菌更易突破免疫防线,引发症状反之,潜伏期可能延长甚至长期隐匿感染总结肺结核潜伏期无固定时长,需结合个体健康状况评估即使处于潜伏期,患者也可能具有传染性,因此早期筛查如结核菌素。
10、部分患者因自身肺泡内巨噬细胞吞噬杀菌能力强,且体质特殊,可能终生都不发病人体抵抗力对潜伏期的影响也十分显著当人体抵抗力下降时,潜伏期可能缩短,最快2 4周就会发病若抵抗力较好,结核分枝杆菌可能处于相对“休眠”状态,患者可能数周数月甚至数十年都不发病由于肺结核潜伏期存在较。
11、肺结核潜伏期是指从结核菌感染人体开始,到出现肺结核临床症状和体征的这段时间影响潜伏期长短的因素结核菌毒力和数量高毒力大量结核菌感染时,免疫系统易被突破,潜伏期缩短低毒力少量菌感染时,免疫系统有更多时间抵抗,潜伏期延长例如,感染高毒力结核分枝杆菌的个体,发病潜伏期可能更。
12、肺结核潜伏期一般为几个月到数年不等,具体时间因人而异肺结核是由结核分枝杆菌引起的呼吸道传染病当感染者吸入含有结核分枝杆菌的飞沫后,结核菌可能在肺部定植并引发感染,但在感染后的一段时间内,患者可能没有任何症状,这段无症状的时期即为潜伏期影响肺结核潜伏期长短的主要因素包括感染。
13、肺结核的潜伏期通常在2 10个月左右,但受多种因素影响,存在个体差异具体如下一般情况免疫力正常的人感染结核分枝杆菌后,可能在3 6个月内发病免疫力较低的人群,如艾滋病患者糖尿病患者等,潜伏期可能缩短,甚至在感染后数周内发病免疫力较强的健康人,潜伏期可能延长至1年甚至更。
14、肺结核的潜伏期并无固定时长,需结合个体情况综合判断1 抵抗力与感染量的双重影响当人体抵抗力较强,且感染的结核杆菌数量较少毒性较弱时,可能长期不发病部分人群甚至终身携带结核杆菌而未出现临床症状,仅在体检或免疫功能下降时通过检查发现2 抵抗力下降与感染量大的风险若患者身体状况较差。
15、3 终身不发病的特殊情况约5%10%的感染者因免疫系统强大,可长期甚至终身携带结核杆菌而不出现临床症状,称为“潜伏性结核感染”LTBI此类人群虽无症状,但体内存在活菌,在免疫功能下降时如艾滋病糖尿病或使用免疫抑制剂可能激活为活动性肺结核关键科普说明肺结核潜伏期指从感染结核杆菌到出现临床疾。
16、最后,肺结核的潜伏期时间不能固定,只要感觉到身体不适,或者是怀疑会被感染的话,就要定期到医院复查,而且避免和家里人有过于亲密的接触,也不要对着孩子或者是家里人咳嗽,预防感冒也是很重要的结核病是由结核分枝杆菌引起的慢性传染病,可侵及许多脏器,以肺部结核感染最为常见排菌者为其重要的。
17、肺结核的潜伏期通常为4至8周结核分枝杆菌感染人体后,并不会立即引发症状,而是进入一个相对隐蔽的潜伏阶段这一阶段的时间跨度大致为4至8周,但具体时长可能因个体差异感染菌量及机体免疫状态等因素而有所不同在潜伏期内,感染者可能并无明显不适,但体内已存在结核分枝杆菌若机体抵抗力不强。
京公网安备11000000000001号
京ICP备11000001号
还没有评论,来说两句吧...